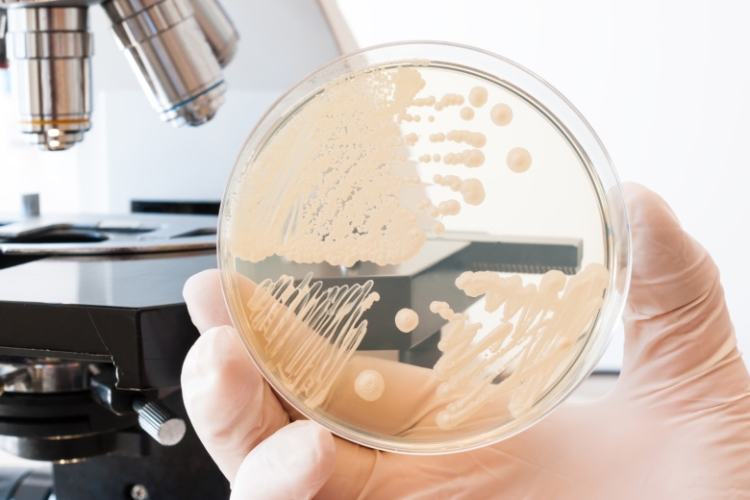
Живет в каждом из нас: чем опасен кандидоз, симптомы, как не заболеть

Кандидоз — инфекционное заболевание, вызываемое дрожжеподобными грибками рода Candida, преимущественно Candida albicans. Они относятся к условно патогенной флоре человека и в норме присутствуют на слизистых оболочках ротовой полости, кишечника, урогенитального тракта и кожи. Врач — акушер-гинеколог Красногорской больницы Минздрава Подмосковья Рафиса Кунафина рассказала в интервью NEWS.ru, при каких условиях размножение грибка выйдет из-под контроля и чем это опасно.
Симптомы кандидоза
Симптоматика заболевания определяется местом поражения. К примеру, урогенитальный кандидоз сопровождается зудом, жжением, отечностью и покраснением слизистых оболочек, появлением характерных творожистых выделений, дискомфортом при мочеиспускании и половом акте. Другой вид — орофарингеальный кандидоз — проявляется белым налетом на слизистых ротовой полости и языке, болезненностью, жжением, нарушением вкусового восприятия. Кандидоз кожи — воспалением, трещинами, зудом, шелушением, преимущественно в межпальцевых и кожных складках; кишечника — вздутием, болями в животе и диареей, а также метеоризмом.

У кого развивается кандидоз в первую очередь
Инфекция развивается преимущественно у пациентов с нарушениями иммунной или гормональной регуляции, а также при дисбактериозе. Однако в группу повышенного риска входят женщины в период беременности, климакса или приема гормональных контрацептивов, пациенты, проходящие длительную антибактериальную или глюкокортикоидную терапию, а также люди с сахарным диабетом, анемией, хроническими заболеваниями. Повышенный риск развития кандидоза наблюдается и у новорожденных, пожилых людей, пациентов с ВИЧ или другими состояниями иммунодефицита.
Следует обратить внимание на то, что комбинация нескольких факторов значительно повышает вероятность развития кандидоза. Заболевание часто отражает и внутреннее истощение организма. Стресс и переутомление снижают иммунитет, и условно патогенная флора начинает активно расти.
Что будет, если кандидоз не лечить
При отсутствии адекватной терапии кандидоз может переходить в хроническую или рецидивирующую форму. Если речь идет о последствиях для женщин, следует отметить, что длительный вагинальный кандидоз вызывает стойкое воспаление слизистых, формирование микротрещин, вторичное бактериальное инфицирование и дисбиоз влагалища. У мужчин грибковая инфекция приводит к баланопоститу, болевым ощущениям, воспалению головки и крайней плоти, в тяжелых случаях — к развитию фимоза.

Когда речь идет о пациентах с ослабленным иммунитетом, возможно формирование системного кандидоза с поражением легких, печени, почек, эндокарда и центральной нервной системы, что представляет угрозу жизни. Даже при локализованных формах заболевание ухудшает качество жизни, вызывает физический и эмоциональный дискомфорт.
Как избежать развития кандидоза
Хорошей профилактикой развития кандидоза является питание. Ограничение продуктов, богатых простыми углеводами (сладости, белый хлеб, дрожжевая выпечка), способствует уменьшению питательной среды для грибов. Рекомендуется включать в рацион овощи, нежирное мясо, рыбу, молочнокислые продукты, богатые пробиотическими культурами (Lactobacillus, Bifidobacterium). Достаточное потребление воды поддерживает здоровое состояние слизистых оболочек.
Кроме того, следует с осторожностью пить антибиотики, так как их нерациональное применение разрушает нормальную микрофлору и способствует росту Candida. При необходимости длительного лечения антибактериальными препаратами рекомендуется параллельный прием пробиотиков и консультация врача.
Следует также отдавать предпочтение хлопковому белью, избегая тесной синтетической одежды, особенно в жаркое время года. Гигиенические средства должны быть мягкими, без агрессивных ароматизаторов и антисептиков.
Регулярная физическая активность, полноценный сон, контроль стрессовых факторов и отказ от курения укрепляют иммунную защиту. Профилактические визиты к гинекологу, урологу или терапевту позволяют своевременно выявить ранние проявления заболевания и предотвратить осложнения.

Чем опасны попытки самолечения при кандидозе
При выявлении кандидоза необходимо обратиться к врачу для проведения диагностики и подбора терапии. Лечение включает местные и системные противогрибковые препараты (в зависимости от локализации процесса), коррекцию сопутствующих нарушений и исключение провоцирующих факторов. Самовольное применение лекарственных средств, особенно антибиотиков и гормональных мазей, недопустимо. Это может привести к устойчивости грибков и рецидиву заболевания.
ВИЧ, импотенция и простатит: чем опасен трихомониаз, можно ли вылечить
Провоцируют рак и диабет: врач назвала самые опасные магазинные продукты
Симптомы, осложнения, чем опасна: терапевт развеяла главные мифы о ветрянке
Как нас пытается обмануть сифилис: симптомы, пути передачи, можно ли лечить
